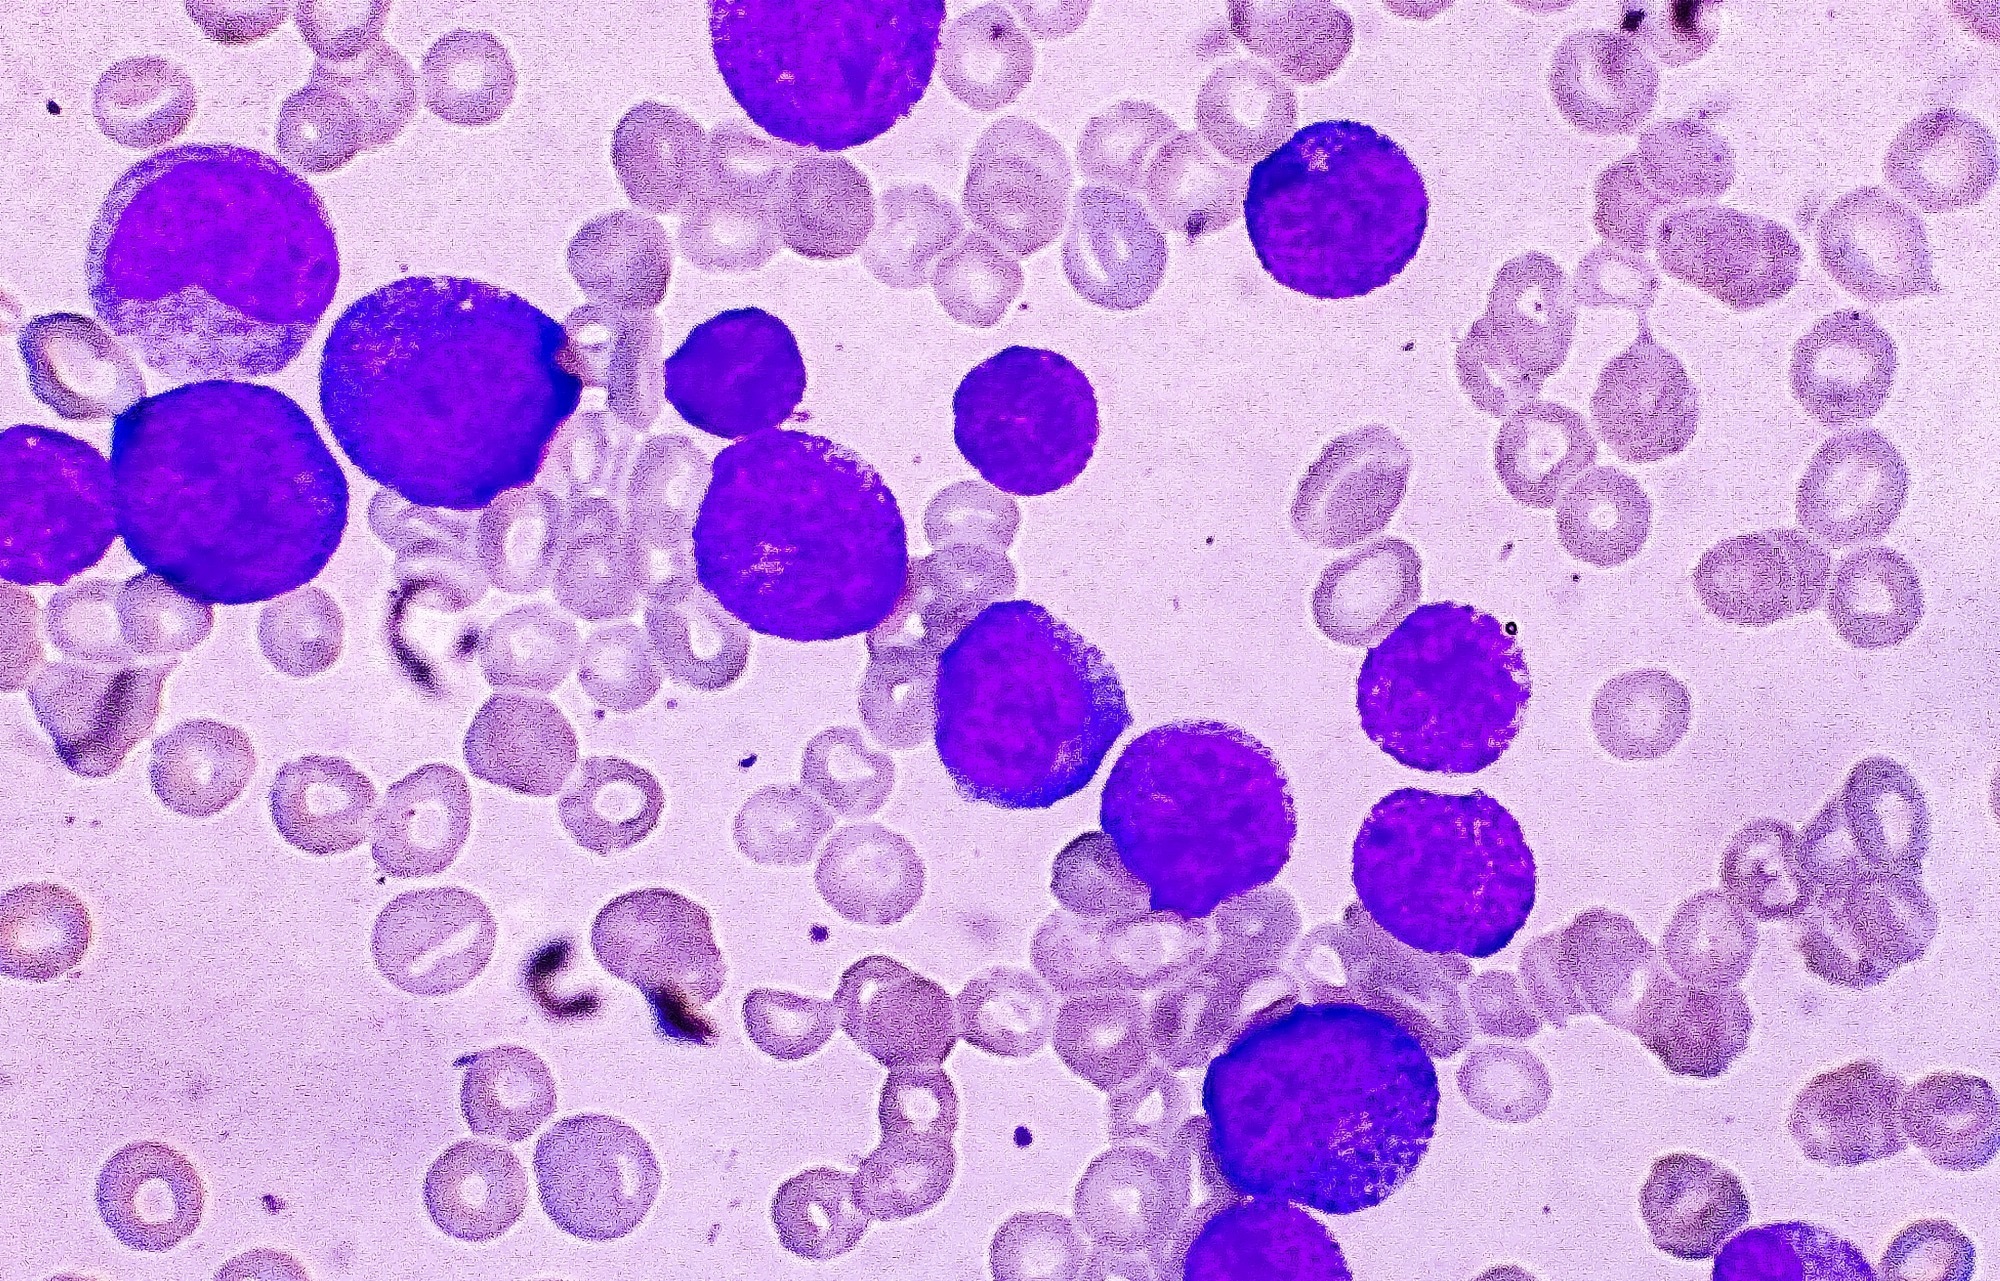

A new nanomaterial triggers a domino effect of chemical reactions inside cancer cells, killing them through oxidative stress and leaving healthy tissues alone.
Study: Structurally Engineered Ferrous Metal–Organic Framework as a Chemodynamic Therapy Nano agent for Concurrent Hydroxyl Radical and Singlet Oxygen Generation. Image Credit: Arif biswas/Shutterstock.com
Study: Structurally Engineered Ferrous Metal–Organic Framework as a Chemodynamic Therapy Nano agent for Concurrent Hydroxyl Radical and Singlet Oxygen Generation. Image Credit: Arif biswas/Shutterstock.com
The study was reported in Advanced Functional Materials by researchers at Oregon State University. Such cancer treatment is known as chemodynamic therapy, and avoiding healthy tissue is a complicated process.
Chemodynamic therapy is a new treatment strategy based on the unique biochemical milieu of cancer cells. The scientists explain that malignant tumors have higher hydrogen peroxide concentrations and are more acidic than healthy cells.
Conventional CDT uses the tumor microenvironment to stimulate the generation of hydroxyl radicals, molecules composed of oxygen and hydrogen with an unpaired electron. These reactive oxygen species can harm cells by oxidation by stealing electrons from components such as lipids, proteins, and DNA.
Recent chemodynamic treatment designs have been able to leverage tumor circumstances to catalyze the synthesis of another reactive oxygen species, singlet oxygen, which is called after its single electron spin state rather than the three states present in more stable oxygen molecules in the air.
However, existing CDT agents are limited. They efficiently generate either radical hydroxyls or singlet oxygen but not both, and they often lack sufficient catalytic activity to sustain robust reactive oxygen species production. Consequently, preclinical studies often only show partial tumor regression and not a durable therapeutic benefit.
Oleh Taratula, College of Pharmacy, Oregon State University
In this study, the scientists introduce a unique CDT nanoagent, an iron-based metal-organic framework (MOF), capable of producing both chemicals for more effective treatment and with higher catalytic efficiency. The MOF exhibited strong toxicity in many cancer cell lines while causing minimal damage to noncancerous cells.
When we systemically administered our nanoagent in mice bearing human breast cancer cells, it efficiently accumulated in tumors, robustly generated reactive oxygen species and completely eradicated the cancer without adverse effects. We saw total tumor regression and long-term prevention of recurrence, all without seeing any systemic toxicity.
Oleh Taratula, College of Pharmacy, Oregon State University
Before using this treatment on patients, the scientists intend to assess its therapeutic efficacy in several cancer types, particularly aggressive pancreatic cancer, to establish its broad applicability across diverse malignancies.
Journal Reference:
Wang, C., et al. (2026) Structurally Engineered Ferrous Metal–Organic Framework as a Chemodynamic Therapy Nanoagent for Concurrent Hydroxyl Radical and Singlet Oxygen Generation. Advanced Functional Materials. DOI: 10.1002/adfm.202529194.